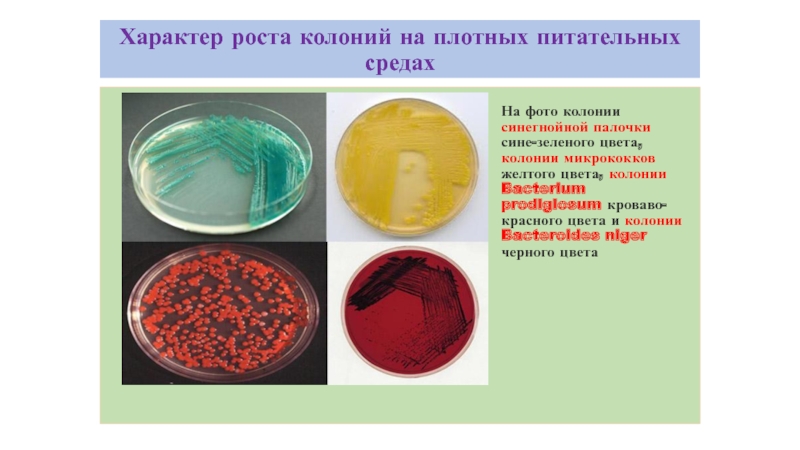

Разделы презентаций
- Разное
- Английский язык
- Астрономия
- Алгебра
- Биология
- География
- Геометрия
- Детские презентации
- Информатика
- История
- Литература
- Математика
- Медицина
- Менеджмент
- Музыка
- МХК
- Немецкий язык
- ОБЖ
- Обществознание
- Окружающий мир
- Педагогика
- Русский язык
- Технология
- Физика
- Философия
- Химия
- Шаблоны, картинки для презентаций
- Экология
- Экономика
- Юриспруденция
Бактериологические методы исследования
Содержание
- 1. Бактериологические методы исследования
- 2. Бактериологическое исследование как анализ
- 3. Культуральные свойства бактерийК культуральным или макроморфологическим свойствам
- 4. Этапы бактериологического исследования1 этап Посев материала на питательные
- 5. Этапы бактериологического исследования2 этапПроводят изучение колоний бактерий,
- 6. Культуральные свойства бактерийПри описании колоний учитывают следующие
- 7. Этапы бактериологического исследования3 этапИдентификация выделенной чистой культуры
- 8. Классификация питательных сред
- 9. Классификация питательных сред
- 10. Классификация питательных сред
- 11. Классификация питательных сред
- 12. Характер роста колоний на жидких питательных средах
- 13. Характер роста колоний на плотных питательных средахНа
- 14. Характер роста бактерий на плотных питательных средахКультура кишечной палочки на среде Эндо
- 15. Кривая роста бактериальной популяции
- 16. Скачать презентанцию
Бактериологическое исследование как анализ
Слайды и текст этой презентации
Слайд 1Бактериологические методы исследования
Бактериологическое исследование — совокупность методов, которые применяют для обнаружения
и распознания природы бактерий, выделенных от бактерионосителей (больных) или из объектов окружающей среды.
исследование проводят с целью диагностики инфекционных заболеваний, а также для определения на бактерионосительство и для определении санитарно-гигиенического состояния окружающей среды.Слайд 3Культуральные свойства бактерий
К культуральным или макроморфологическим свойствам относятся характерные особенности
роста микроорганизмов на плотных и жидких питательных средах.
Колонии, выросшие на
поверхности среды, отличаются разнообразием, они видоспецифичны и их изучение используется для определения видовой принадлежности исследуемой культуры.Колонией называют изолированное скопление клеток одного вида, выросших из одной клетки (клон клеток).
Слайд 4Этапы бактериологического исследования
1 этап
Посев материала на питательные среды производят либо
стеклянным или металлическим шпателем, либо бактериальной петлей таким образом, чтобы
находящиеся в исследуемом материале бактерии рассеять по поверхности питательной среды. В результате такого рассеивания каждая бактериальная клетка попадает на свой участок среды.Слайд 5Этапы бактериологического исследования
2 этап
Проводят изучение колоний бактерий, выросших на плотной питательной
среде и происходящих от одной бактериальной клетки. (колония и является чистой культурой возбудителя).
Производят микроскопическое и макроскопическое исследование колоний в отраженном и проходящем свете: невооруженным глазом, под малым увеличением микроскопа, с помощью лупы.Каждая колония — потомство одной-единственной клетки. В колонии число клеток исчисляется миллионами. вырастает колония за 1 — 3 суток.
Слайд 6Культуральные свойства бактерий
При описании колоний учитывают следующие признаки˸
Форму колонии -
округлая, амебовидная, ризоидная , неправильная и т.д.;
Размер (диаметр) колонии -
очень мелкие (точечные) (0,1-0,5 мм), мелкие (0,5-3 мм), средних размеров (3-5 мм) и крупные (более 5 мм в диаметре);Поверхность колонии - гладкая, шероховатая, складчатая, морщинистая, с концентрическими кругами или радиально исчерченная;
Профиль колонии - плоский, выпуклый, конусовидный, кратерообразный и т.д.;
Прозрачность - тусклая, матовая, блестящая, прозрачная, мучнистая;
Цвет колонии (пигмент) - бесцветная или пигментированная (белая, желтая, золотистая, красная, черная), особо отмечают выделение пигмента в среду с ее окрашиванием;
Край колонии - ровный, волнистый, зубчатый, бахромчатый и т.д.;
Структура колонии - однородная, мелко или крупнозернистая, струйчатая; край и структуру колонии определяют с помощью лупы или на малом увеличении микроскопа, поместив чашку Петри с посевом на столик микроскопа крышкой вниз;
Консистенция колонии - определяют прикасаясь к поверхности петлей, колония должна быть плотной, мягкой, врастающей в агар , слизистой (тянется за петлей), хрупкой (легко ломается при соприкосновении с петлей).